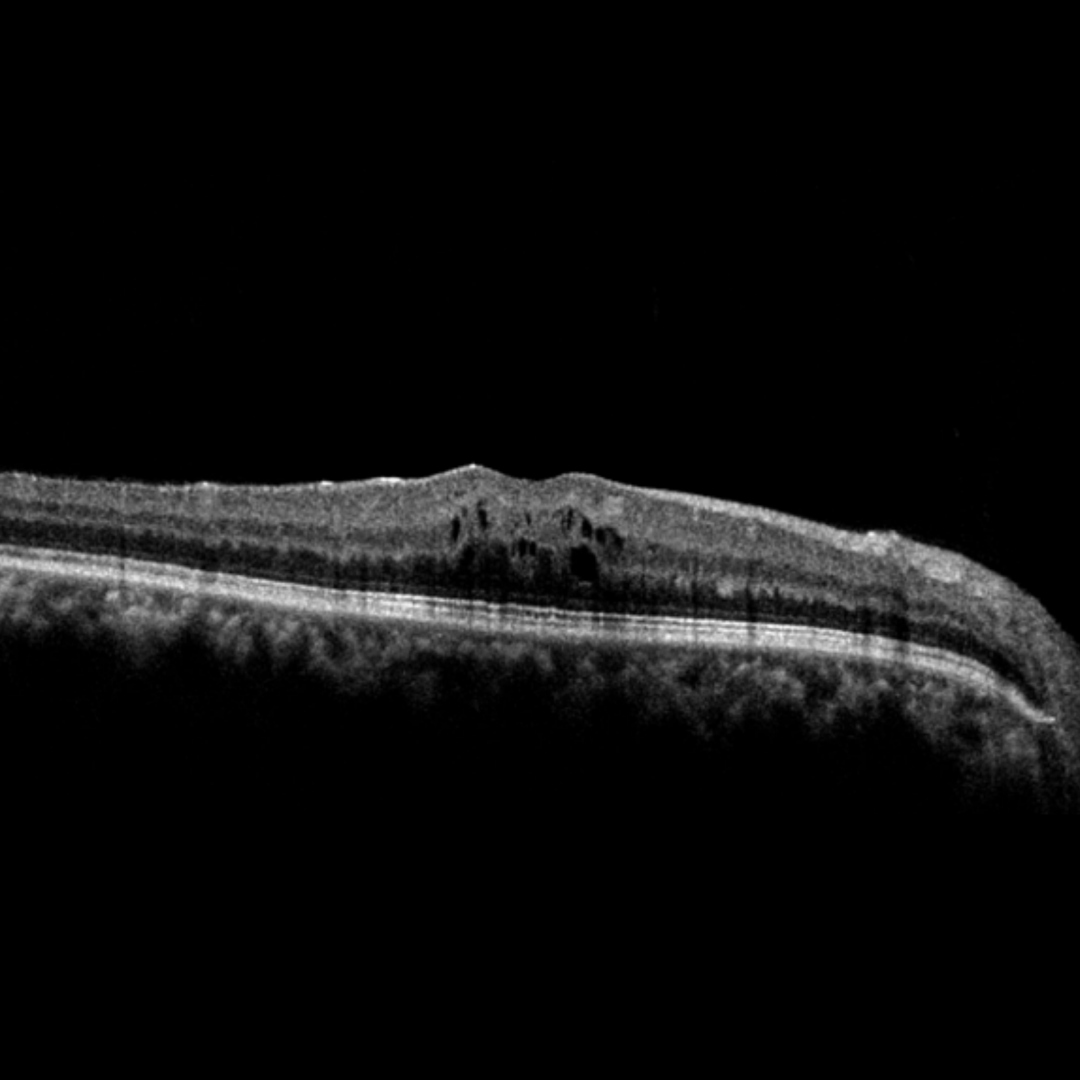

- Overview
- Pathophysiology
- Acute Presentation
- Collateral Vessels
- Retinal Neovascularisation
- Macular Oedema
- Ischaemic vs Non-ischaemic
- Sub-Topics
- References
Overview

Retinal venous occlusion is described in terms of the location of the occlusion. A central retinal vein occlusion (CRVO) is caused by an occlusion located posterior to the lamina cribosa - a condition that affects the flow of blood out of the eye from all veins.
A hemiretinal vein occlusion (HRVO) refers to a blockage of either the superior or inferior branch of the central retinal vein, affecting blood flow out of one half of the retina.
A branch retinal vein occlusion (BRVO) in contrast refers to the obstruction of blood flow through one of the smaller retinal veins, affecting blood flow from a discrete area of the retina.
Pathophysiology

Over time, arterioles harden and become thicker. This can result in compression of the underlying vein at the point where the vessels cross. The overlying pressure acts to reduce the diameter of the vein (referred to as the lumen), restricting the flow of blood through this vessel. If there is complete obstruction of the vessel, it is referred to as a branch retinal vein occlusion.
When this same compressive occlusion occurs posterior to the lamina cribosa it is known as a central retinal vein occlusion. At this point, all the retinal veins have converged to form a single larger vein draining blood away from the retina and the central retinal artery and vein share a common adventitial sheath.
Another potentially causative factor is the development of a thrombus (or blood clot) that further narrows the intraluminal space. There are three contributory factors to the development of a thrombosis - interrupted blood flow (venous stasis), damage to the vessel endothelium and blood hyper-coagulability. It is also important to note that patients with intraocular pressures above 30mmHg are prone to developing venous thrombosis.
With all types of venous occlusion, the narrowing of the intraluminal space causes an increase in intraluminal pessure, resulting in the tansudation of blood and associated products including protein into the surrounding retina. The increased protein content in the surrounding retina can cause an osmotic pressure gradient, resulting in more fluid being drawn into the retina and further increasing retinal oedema.
Acute Presentation

The clinical appearance of retinal vein occlusions change over time. Acute presentations are characterised by widespread retinal haemorrhages, including blot, dot and flame haemorrhages.
Cotton wool spots may be present, as may retinal or macula oedema (this is covered in more depth further down this page).
Central retinal vein occlusions also have an associated elevation of the optic nerve head.
Over time, the retinal haemorrhages associated with an acute venous occlusion are reabsorbed. Macular oedema may persist and other vascular changes can occur, including the development of either collateral vessels or neovascular vessels.
Collateral Vessels

Collateral vessels form between patent and non-patent blood vessels to re-establish blood flow to areas of ischaemic retina. The formation of these vessels reduce the risk of irreversible tissue damage and are a positive sign.
The vessels themselves appear on retinal photos as loopy, slightly dilated vessels in the area of previous occlusion (1,2).
On OCT they may be seen to be located in the inner retina (adjacent to the normal retinal vasculature from which they arise (3). OCTA shows the looped nature of the collateral vessels superior to the disc (4).
Retinal Neovascularisation

Retinal hypoxia and the associated release of VEGF can result in retinal or iris neovascularisation. These vessels are immature, weak and leaky.
Neovascularisation can be a challenge to identify on retinal photography as the vessels as the vessels are typically very fine and thin (1). A red-free filter (or green separation widefield image) may help in identifying these vessels (2).
On OCT, these vessels may be seen on the retinal surface (3) or growing along the posterior hyaloid interface.
Retinal neovascularisation typically occurs within the first 6-12 months following retinal occlusion, however it may occur as late as 3 years after an episode. Retinal neovascularisation may result in tractional retinal detachment and/or pre-retinal and vitreous haemorrhage. Neovascularisation of the iris may result in rubeotic glaucoma.
Ischaemic retinal venous occlusions are most likely to lead to the development of neovascularisation.
Macular Oedema
Macular oedema may be associated with either chronic or acute presentations of venous occlusion. Chronic macular oedmea is the most common cause of persistantly reduced visual acuity following a central retinal vein occlusion.
Increased intraluminal pressure as the result of a venous occlusion causes leakage of lipids, proteins and serous fluid into the retina. The clinical signs of macular oedema may include the following:
1. Hard exudates: visible on retinal photography, these lesions are an indication of past or present macular oedema. They present clinically as discrete, yellow-white lipid deposits and may be isolated, diffuse, circinate (circular), or star-shaped. On OCT, hard exudates appear as hyper-reflective deposits in the outer plexiform layer (OPL) or outer nuclear layer (ONL).
2. Retinal thickening and Intraretinal cystic spaces: Seen on OCT as hypo reflective areas within the retina. It is possible to have intra retinal oedema present without hard exudates being visible.
Ischaemic vs Non-ischaemic
Retinal venous occlusions may be either ischaemic or non-ischaemic and this has a significant bearing on prognosis - both in terms of vision loss and also complications such as retinal neovascularisation.
The presence or otherwise of cotton wool spots is not an accurate indicator of the ischaemic nature of a venous occlusion. Fluorescein angiography is required to determine whether an occlusion is ischaemic or not.
It is important to note that occlusions that are non-ischaemic at presentation may become ischaemic over time with 15% of non-ischaemic CRVO converting to ischaemic CRVO in 3-4 months and 34% converting within 3 years (CVO Study Group, 1997). For this reason, it is important to routinely review all cases of previous retinal vein occlusion for signs of disc and retinal neovacularisation or rubeosis irides.
Sub-Topics
References
Jia Li, Yannis M. Paulus, Yuanlu Shuai, Wangyi Fang, Qinghuai Liu, and Songtao Yuan (2017) New Developments in the Classification, Pathogenesis, Risk Factors, Natural History, and Treatment of Branch Retinal Vein Occlusion. Journal of Ophthalmology Volume 2017 |Article ID 4936924.
Khayat, Survey Ophth 2018. Major Review: Ischemic retinal vein occlusion: characterising the more severe spectrum of retinal vein occlusion
Patel, A., Nguyen, C., & Lu, S. (2016). Central Retinal Vein Occlusion: A Review of Current Evidence-based Treatment Options. Middle East African journal of ophthalmology, 23(1), 44–48.
Woo, S., Lip, G. & Lip, P. (2016) Associations of retinal artery occlusion and retinal vein occlusion to mortality, stroke, and myocardial infarction: a systematic review. Eye 30, 1031–1038.


